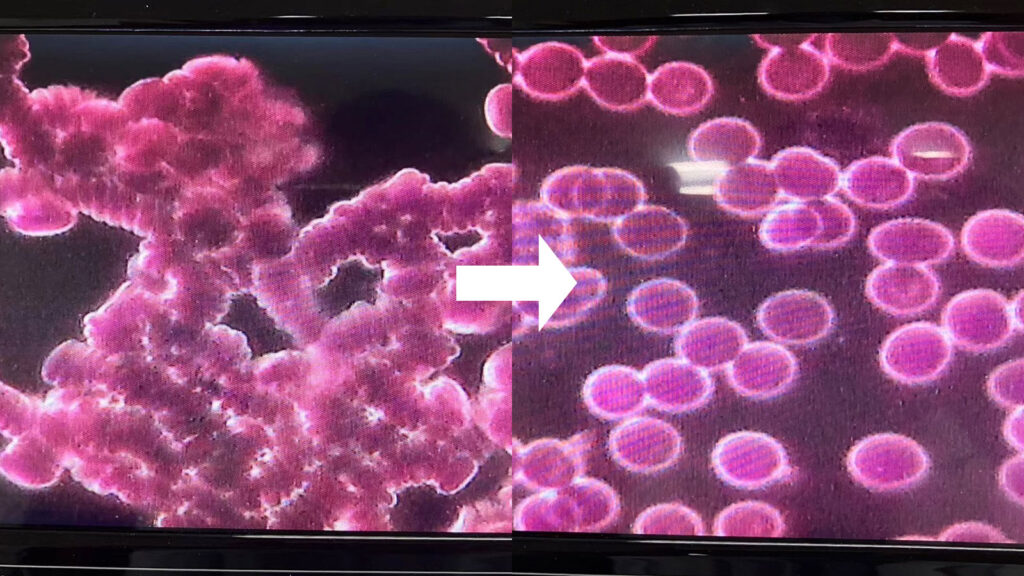

初めは皆さん半信半疑だったんですが…
究極の健康法に出会えました!
20代女性 OL
今まで、健康と美容の為にジムに通ったり、美容機器を使ってきましたが、なかなか続けることができませんでした。
DENBA Healthはただ寝るだけ、座るだけなので、続かない日が1日も有りません!しかもDENBA空間にいるだけでも良いということが最大のメリットだと思います。
ただ居るだけで嬉しい体感が得られるのは、主婦の味方です!
30代女性 主婦
DENBA Healthと出会って若々しさ今のままのコンセプトに、本当なの?と心配をしましたが、主人にも子供にも使ってよかったねママ!と言ってくれるようになりました。
何もしなくても、ただ居るだけで嬉しい体感が得られるのは、主婦の味方です!また、子供も一緒に使える為、一緒にウトウトしてしまい、お昼寝してしまいます。それだけでもお部屋が至福の空間になりました。
自分の顔が若々しく、これは非常に驚きました。
40代男性 会社員
会社でも仕事中に使用しています、朝が早くお昼休憩後には眠くなってしまって、あくびをすることもしばしば、DENBA Healthを使用して、あくびもすることが無くなり、就業時間でも、電車のガラス越しに見えた自分の顔が若々しく、これは非常に驚きました。
たまにスイッチを入れ忘れた時は、あくびをしてしまうので直ぐにDENBAエネルギーを即Chargeしたい!と思うようになりました。
DENBAとは?
体内の水分子にアプローチし、
細胞レベルで活性化
特許をとった技術を「ヒト」にも応用。 細胞レベルで活性化を促し健康寿命を延ばし、 クオリティ・オブ・ライフの向上を実現。 産学連携により科学的研究をすすめるほか、 エビデンスも獲得してきました。


睡眠や体調で
こんなお悩み
ありませんか?



夜ぐっすり眠れない、何度も中途覚醒してしまう
朝起きた時に疲れが取れていない
どこか体の不調を感じている
知っていますか?

日本人の睡眠を解き明かすと…
日本は多くの人が「何らかの睡眠の悩みがある」と回答しています。日本人、特に就労者の睡眠時間は世界で最も短いと言われており、就労者の男女別の睡眠時間を国際比較しても日本人の睡眠時間が如何に短いかがわかります。
また、加齢によって睡眠のお悩みは増加する傾向にあり、特に60歳以上の方で顕著に多くなると言われています。

高齢者の睡眠
睡眠は年齢とともに変化していきます。健康な高齢者の方でも、 歳をとると睡眠が浅くなり、中途覚醒や早朝覚醒が増加します。睡眠脳波をみると、深いノンレム睡眠が減り、浅いレム睡眠が 増えるようになります。
そのため、尿意や小さい物音などでも、 目が覚めてしまうようになります。


人生のうち3分の1は睡眠に時間を使っているため
この睡眠時間が充実すると人生は大きく変わります!
なぜDENBAが選ばれるのか?

始まりは食品の鮮度保持を可能にした特許技術
DENBAはもともと食品の鮮度保持を目的に開発されました。
低周波を用いて空間中の水分子を振動させる独自技術(DENBA技術)を確立し、これを活用して食品分野における鮮度維持を実現。特に肉類、魚介類、青果物などの生鮮食品の品質保持に大きな成果を上げています。
この鮮度保持技術を人体へ応用したのがDENBA Healthです。
DENBA Healthは、マットから360度に広がる超低周波の電場空間を生成します。この空間に身を置くことで、体内の水分子が緩やかに振動し、心身の健康維持をアシストします。
▲マグロの切り身をDENBA空間に設置した場合の保存比較実験
DENBA空間に設置したアジサイの変化

DENBAを使用したときの赤血球の変化
東京大学との共同研究によるDENBAの技術で、自律神経の活動が高まる
自律神経のパワーは40代で半分に、50代になると3分の1まで落ちてしまいます。この時期から更年期障害等で悩む方が急に増えてきます。
DENBAは東京大学と伊藤忠商事株式会社との共同研究により、 15分程度の電場印加が、 自律神経(交感神経・副交感神経の双方)の活動を 高めることを確認しています。

驚くべきDENBAの秘密を公開

金メダリストも使用
前十字靭帯の怪我を経て、通常は復帰に1年以上の期間を要するものの、10ヶ月ほどで以前の練習量に戻すことができ、周囲を驚愕させる。
2024年パリ五輪 金メダル獲得。
鮮度保持・抗酸化ケア
ただDENBA空間にいるだけで、健康・エイジングケア・美容をサポート。人生100年時代のパートナーとして、空間中の生命体の鮮度保持を協力にサポート。

動物へのストレス緩和
麻布大学との研究では、豚のストレス緩和に関する実証データを取得いたしました。
DENBA空間に居るだけで動物のストレスを緩和し、犬・猫・鳥など様々な動物にDENBAは使用可能。
メディア事例


SDGsへの取り組み

研究結果にも
プロフェッショナルにも認められた
唯一無二のヘルスケアデバイス
”DENBA”

だから、結果が違います。
未来のご自身と家族への健康投資として
ぜひご活用下さい。
夜ぐっすり眠れない、何度も中途覚醒してしまう
朝起きた時に疲れが取れていない
どこか体の不調を感じている

こんな方はDENBAをお試しください。
製品紹介
DENBA Health Charge(デンバヘルス チャージ)

販売価格:オープン価格
| 型番 | DENBA-08DC1 |
| 寸法 | W187mm×D110mm×H59mm |
| 入力電圧 | AC100V 50/60Hz AC220-240V 50Hz |
| 消費電力 | 2W |
| 重量 | 1.8kg |
敷きマット Bタイプ
| 寸法 | W600mm×D1200mm×H10mm |
敷きマット Cタイプ
| 寸法 | W120mm×D1200mm×H10mm |






DENBA Health Standard(デンバヘルス スタンダード)

販売価格:550,000円(税込)
| 型番 | DENBA-08H-19 |
| 寸法 | W165mm×D190mm×H96mm |
| 入力電圧 | 100〜115V 220〜240V 50/60Hz |
| 重量 | 2.9kg |
敷きマット Aタイプ
| 型番 | DBH-50S |
| 寸法 | W50cm×D50cm×H1cm |
敷きマット Bタイプ
| 型番 | DBH-60S |
| 寸法 | W60cm×D120cm×H1cm |
敷きマット Cタイプ
| 型番 | DBH-120S |
| 寸法 | W120cm×D120cm×H1cm |






DENBA Health High-grade(デンバヘルス ハイグレード)

販売価格:900,000円(税込)
| 型番 | DENBA-08H-H |
| 寸法 | W188mm×D243mm×H154mm |
| 入力電圧 | 100~120V 50/60Hz |
| 重量 | 3.8kg |
敷きマット Dタイプ
| 型番 | DBH-60S |
| 寸法 | W60cm×D120cm×H1cm |
敷きマット Eタイプ
| 型番 | DBH-120S |
| 寸法 | W120cm×D120cm×H1cm |





まずはDENBAの効果を試してみたいあなたに
月額6,600円のサブスクプランでお試し!




DENBA Mobile(デンバ モバイル)

DENBAを購入してみたいけど、迷っている方へ。
月額6,600円でDENBAの効果を気軽に実感できるプランをご用意しました。
DENBA Mobileは小型で軽量。気軽に持ち運びが可能でDENBAの効果をすぐに実感できます。
DENBAご利用者様の声
究極の健康法に出会えました!
20代女性 OL
今まで、健康と美容の為にジムに通ったり、美容機器を使ってきましたが、なかなか続けることができませんでした。
DENBA Healthはただ寝るだけ、座るだけなので、続かない日が1日も有りません!しかもDENBA空間にいるだけでも良いということが最大のメリットだと思います。
ただ居るだけで嬉しい体感が得られるのは、主婦の味方です!
30代女性 主婦
DENBA Healthと出会って若々しさ今のままのコンセプトに、本当なの?と心配をしましたが、主人にも子供にも使ってよかったねママ!と言ってくれるようになりました。
何もしなくても、ただ居るだけで嬉しい体感が得られるのは、主婦の味方です!また、子供も一緒に使える為、一緒にウトウトしてしまい、お昼寝してしまいます。それだけでもお部屋が至福の空間になりました。
自分の顔が若々しく、これは非常に驚きました。
40代男性 会社員
会社でも仕事中に使用しています、朝が早くお昼休憩後には眠くなってしまって、あくびをすることもしばしば、DENBA Healthを使用して、あくびもすることが無くなり、就業時間でも、電車のガラス越しに見えた自分の顔が若々しく、これは非常に驚きました。
たまにスイッチを入れ忘れた時は、あくびをしてしまうので直ぐにDENBAエネルギーを即Chargeしたい!と思うようになりました。
これが世界レベルの鮮度保持技術だと感動いたしました。
50代女性 会社員
代謝も落ちて運動不足の中で、何もせずとも全身が振動することに非常に驚きました。低電位ですので、ペットも一緒に使用できますので安心して使用できます。
また、お庭のアジサイを採取してDENBA有りと無しで飾っていましたら、通常は9日で劣化しましたが、DENBA空間は新鮮そのもの!これが世界レベルの鮮度保持技術だと感動いたしました。
自宅の水槽の水の劣化も抑えられ、本当に驚きでした!
60代男性 会社員
タクシー運転手をしています。勤務時間もバラバラで体内時計が不安定な中で、体調整えるために、健康器具を探していました。DENBA Healthは、何もせずとも健康サポートできると言うことが、直ぐに飽きてしまう私は最大のメリットだと感じています。
1年間使用していますが、1日も使用しない日は有りません。DENBA空間にある、自宅の水槽の水の劣化も抑えられ、本当に驚きでした!
世界でも選ばれるDENBA
全世界で10万台突破
全世界累計10万台突破、日本を中心に、アジア、ヨーロッパ、アメリカなど様々な国でDENBA Healthをご愛用頂いております。また、一般のご家庭から、治療器としての設備、トップアスリートの日常のケアにも、使用用途は様々です。また、人だけではなく、犬や猫、馬など動物にもご使用いただいております。

DENBAが
ある生活


簡単に実現
いただけます
DENBAの使い方

10秒で、誰でもかんたん設置
DENBAは機械とマットを繋いで、 電源を入れるだけで簡単に使えます。

マットが快適な“空間”を作成
DENBAマットが超低周波を360°発振。 快適な空間を広範囲に作り出します

場所を選ばず、どこでも使用
リビング、寝室などコンセントがあればどこでも使用可能です。家になじんで生活に潤いを与えてくれます。

子ども・ご年配・ペットでも
DENBA HealthはPSEマーク取得。 低電圧で体にやさしいので、小さなお子様や ペットがいるご家庭でも安心にかかれます。

月の電気代20円と家計に優しい
DENBAは24時間かけっぱなしが可能。それでも電気代はなんと月20円と、家計に優しい金額です。

AMラジオよりも低い電磁波
DENBA製品から出る電磁波は、AMラジオよりも低く、人体にもほとんど影響がないレベルといえます。
超低周波電磁界とは・・・ 商用周波数(50/60Hz)の電磁波は 超低周波(ELF:Extremely Low Frequency) 電磁界とも呼ばれています。 超低周波(ELF)電磁界の波長は 6,000km/5,000kmと地球の半径ほどの長さなので、 例えば送電線の近くでも電波などとは異なり 波の性質が非常に小さくなります。
安心のお約束
私達はセールスはいたしません。
食品の鮮度保持技術として始まったDENBAは、2018年にヘルスケア市場に参入。
皆様から高い評価を受け、おかげさまで、10万台の実績を達成しました。
広告宣伝をほとんど行っていないにも
関わらず、なぜ10万台以上が売れたのか。
それは、「結果」という
真実があったからです。

ただ、お困りのことがございましたら、お気軽にご相談下さい。
知識豊富なプロフェッショナルが、柔軟にご案内いたします。
ただ、お困りのことがございましたら、お気軽にご相談下さい。
知識豊富なプロフェッショナルが、柔軟にご案内いたします。

よくあるご質問
- DENBAの技術とは何でしょうか?
対象物の水分子に微細な振動を与えることができます。その結果、さまざまな健康に対するお悩みのサポートができると考えております。
- DENBAの使用方法をおしえてください。
本体とマットを白コードでつないで、100Vコンセントを差して本体のスイッチを入れてください。マットの上に座ったり寝たりすればご使用いただけます。また、マットと体を直接ふれなくても、DENBA空間内でしたら大丈夫です。
- DENBA空間の範囲はどのくらいでしょうか?
状況によっても変化はありますが、マットの端から約1m~最大でも1.5m。マットの面から約1m~最大でも1.5mがDENBA空間になります。
- どんな効果がありますか?
DENBA空間にいることで、健康をサポートし特に翌日の目覚めがすっきりします。また、エイジングケアのサポートも致します。
- 自分の健康状態に合わせてカスタマイズできますか?
商品スペックのカスタマイズは不可となります。商品スペックの中の電圧の強さを目安に参考にしてください。
- 使ってはいけない人はいますか?
ペースメーカーなどの体内植込型医用電気機器や、心電計などの装着型医用電気機器などの医用電気機器を使用している場合は、絶対に使用しないでください。
- 体内に人工関節や金属が入っている場合は使えますか?
ペースメーカーなどの体内植込型医用電気機器や、心電計などの装着型医用電気機器などの医用電気機器を使用している場合は使用できませんが、人工関節や金属が入っている場合はお使いいただけます。
- メンテナンス方法は?
マットのみ手洗いにて洗浄可能です。(ただしソケット部分は濡れないように対応お願いします。)
- 24時間ずっと使ってても体に悪影響はありませんか?
24時間ご使用頂くことが出来ます。
- 赤ちゃんやペットが近くにいても問題ありませんか?
赤ちゃんやペットのもご使用いただくことができます。
- 車で使用する方法を教えてください。
正弦波のインバーターを接続して使用する必要があります。※運転中でのご使用はご遠慮ください。必ず車を停車した状態でご使用ください。
未来のご自身と家族への健康投資として、
ぜひご活用下さい。
DENBA Health Charge(デンバヘルス チャージ)

販売価格:オープン価格
| 型番 | DENBA-08DC1 |
| 寸法 | W187mm×D110mm×H59mm |
| 入力電圧 | AC100V 50/60Hz AC220-240V 50Hz |
| 消費電力 | 2W |
| 重量 | 1.8kg |
敷きマット Bタイプ
| 寸法 | W600mm×D1200mm×H10mm |
敷きマット Cタイプ
| 寸法 | W120mm×D1200mm×H10mm |






DENBA Health Standard(デンバヘルス スタンダード)

販売価格:550,000円(税込)
| 型番 | DENBA-08H-19 |
| 寸法 | W165mm×D190mm×H96mm |
| 入力電圧 | 100〜115V 220〜240V 50/60Hz |
| 重量 | 2.9kg |
敷きマット Aタイプ
| 型番 | DBH-50S |
| 寸法 | W50cm×D50cm×H1cm |
敷きマット Bタイプ
| 型番 | DBH-60S |
| 寸法 | W60cm×D120cm×H1cm |
敷きマット Cタイプ
| 型番 | DBH-120S |
| 寸法 | W120cm×D120cm×H1cm |






DENBA Health High-grade(デンバヘルス ハイグレード)

販売価格:900,000円(税込)
| 型番 | DENBA-08H-H |
| 寸法 | W188mm×D243mm×H154mm |
| 入力電圧 | 100~120V 50/60Hz |
| 重量 | 3.8kg |
敷きマット Dタイプ
| 型番 | DBH-60S |
| 寸法 | W60cm×D120cm×H1cm |
敷きマット Eタイプ
| 型番 | DBH-120S |
| 寸法 | W120cm×D120cm×H1cm |





まずはDENBAの効果を試してみたいあなたに
月額6,600円のサブスクプランでお試し!




DENBA Mobile(デンバ モバイル)

DENBAを購入してみたいけど、迷っている方へ。
月額6,600円でDENBAの効果を気軽に実感できるプランをご用意しました。
DENBA Mobileは小型で軽量。気軽に持ち運びが可能でDENBAの効果をすぐに実感できます。





